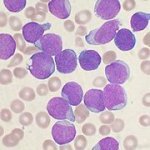
Пугающее слово "лейкоз", что это за болезнь

Вот и наступила желаемая беременность и долгожданный декретный отпуск! Но когда наступил этот момент, вы растерялись и не знаете, чем заняться в декретном отпуске! На самом деле есть очень много разных способов, чтобы занять себя, которые принесут вам лишь позитивное настроение и душевный покой.
Вот и наступила желаемая беременность и долгожданный декретный отпуск! Но когда наступил этот момент, вы растерялись и не знаете, чем заняться в декретном отпуске! На самом деле есть очень много разных способов, чтобы занять себя, которые принесут вам лишь позитивное настроение и душевный покой.
 Молочница, или вагинальный кандидоз, - очень распространенное заболевание. По некоторым данным почти 80% всех женщин хоть раз в жизни сталкивались с ее проявлениями.
Молочница, или вагинальный кандидоз, - очень распространенное заболевание. По некоторым данным почти 80% всех женщин хоть раз в жизни сталкивались с ее проявлениями.
 Воспаление яичников бывает острым, подострым и хроническим. Возникает воспаление обычно, если ваш иммунитет ослаб, переохладились, либо повредили матку механическим воздействием (при аборте, установке маточной спирали или роды).
Воспаление яичников бывает острым, подострым и хроническим. Возникает воспаление обычно, если ваш иммунитет ослаб, переохладились, либо повредили матку механическим воздействием (при аборте, установке маточной спирали или роды).
 К 50 годам у женщины наступает не очень легкий период – женский климакс. Это говорит о том, что репродуктивная фаза женщины заканчивается и переходит в новый этап – окончание менструального цикла.
К 50 годам у женщины наступает не очень легкий период – женский климакс. Это говорит о том, что репродуктивная фаза женщины заканчивается и переходит в новый этап – окончание менструального цикла.
 Причины мастопатии разнообразны, но, в основном, развитие заболевания вызывает резко изменившийся гормональный фон в организме женщины. Это может произойти в разные периоды — и при половом созревании девушки, и после родов или абортов, и перед наступлением менопаузы. По каким бы причинам не возникала мастопатия современные методы лечения позволяют улучшить состояние женщины и вылечить заболевание.
Причины мастопатии разнообразны, но, в основном, развитие заболевания вызывает резко изменившийся гормональный фон в организме женщины. Это может произойти в разные периоды — и при половом созревании девушки, и после родов или абортов, и перед наступлением менопаузы. По каким бы причинам не возникала мастопатия современные методы лечения позволяют улучшить состояние женщины и вылечить заболевание.
 Замершей беременностью называют прекращение внутриутробного развития и гибель плода. Чаще всего замершая беременность бывает на сроках 6-12 недель, но бывает и на сроке беременности до 28 недель, и более поздних. Диагностированная у женщины замершая беременность на поздних сроках - сигнал к срочному оперативному вмешательству по родоразрешению, или стимуляции родовой деятельности искусственно для извлечения погибшего плода.
Замершей беременностью называют прекращение внутриутробного развития и гибель плода. Чаще всего замершая беременность бывает на сроках 6-12 недель, но бывает и на сроке беременности до 28 недель, и более поздних. Диагностированная у женщины замершая беременность на поздних сроках - сигнал к срочному оперативному вмешательству по родоразрешению, или стимуляции родовой деятельности искусственно для извлечения погибшего плода.
 Повреждение слизистой оболочки шейки матки называется эрозия. Эрозия шейки матки является самым распространенным женским заболеванием. Невооруженным глазом, с помощью зеркал, при гинекологическом осмотре можно увидеть на бледно-розовой слизистой шейке матки участки ярко-красного цвета, возникающие из-за нарушения целостности покровной ткани, при отторжении клеток эпителия. Эпителий истончается, обнажается поверхность слизистой оболочки, и она становится доступной для инфекций.
Повреждение слизистой оболочки шейки матки называется эрозия. Эрозия шейки матки является самым распространенным женским заболеванием. Невооруженным глазом, с помощью зеркал, при гинекологическом осмотре можно увидеть на бледно-розовой слизистой шейке матки участки ярко-красного цвета, возникающие из-за нарушения целостности покровной ткани, при отторжении клеток эпителия. Эпителий истончается, обнажается поверхность слизистой оболочки, и она становится доступной для инфекций.
 Понятие «эндометриоз» вошло в медицину совсем недавно – несколько десятков лет назад. Сегодня эта патология является самой распространённой среди всех гинекологических заболеваний, известно действие эндометриоза на женский организм и возникновение большого числа осложнений. К сожалению, точной причины возникновения эндометриоза до сих пор не выявлено. Но медицина имеет методы борьбы с этим заболеванием, которые включают в себя также народные рецепты лечения эндометриоза.
Понятие «эндометриоз» вошло в медицину совсем недавно – несколько десятков лет назад. Сегодня эта патология является самой распространённой среди всех гинекологических заболеваний, известно действие эндометриоза на женский организм и возникновение большого числа осложнений. К сожалению, точной причины возникновения эндометриоза до сих пор не выявлено. Но медицина имеет методы борьбы с этим заболеванием, которые включают в себя также народные рецепты лечения эндометриоза.
 Около половины женщин страдают воспалительными заболеваниями. Воспаление влагалища занимают первое место среди гинекологических заболеваний. Наиболее часто воспаление возникает из-за инфекции.
Около половины женщин страдают воспалительными заболеваниями. Воспаление влагалища занимают первое место среди гинекологических заболеваний. Наиболее часто воспаление возникает из-за инфекции.
 При лечении доброкачественной опухоли груди – мастопатии - средствами народной медицины в сборы обязательно должны входить травы, которые способствуют очищению организма. Это мочегонные, желчегонные, послабляющие, общеукрепляющие и успокаивающие: корень лопуха, одуванчик, календула, зверобой, бессмертник, крапива, черная смородина, шиповник, пустырник, дягиль, корень валерианы. Но перед этим желательно изучить все противопоказания и соответствовать рецептуре в точности.
При лечении доброкачественной опухоли груди – мастопатии - средствами народной медицины в сборы обязательно должны входить травы, которые способствуют очищению организма. Это мочегонные, желчегонные, послабляющие, общеукрепляющие и успокаивающие: корень лопуха, одуванчик, календула, зверобой, бессмертник, крапива, черная смородина, шиповник, пустырник, дягиль, корень валерианы. Но перед этим желательно изучить все противопоказания и соответствовать рецептуре в точности.
 Заболевания вульвы инфекционной природы являются самыми частыми в практике гинеколога. В эту группу входят самые распространенные формы вагинитов – грибковый (кандидозный), трихомонадный и различные бактериальные вульвовагиниты. Смешанные их формы, вызванные одновременно группой микробных агентов, встречаются с частотой до 30% .
Заболевания вульвы инфекционной природы являются самыми частыми в практике гинеколога. В эту группу входят самые распространенные формы вагинитов – грибковый (кандидозный), трихомонадный и различные бактериальные вульвовагиниты. Смешанные их формы, вызванные одновременно группой микробных агентов, встречаются с частотой до 30% .
 Современные женщины настолько заняты работой и повседневными бытовыми хлопотами, что порой задуматься о здоровье буквально не хватает времени. Но согласитесь, любую болезнь легче предупредить, чем потом долгие месяцы, а то и годы лечить ее. В рейтинге самых нелюбимых врачей первые строчки занимают стоматологи и гинекологи.
Современные женщины настолько заняты работой и повседневными бытовыми хлопотами, что порой задуматься о здоровье буквально не хватает времени. Но согласитесь, любую болезнь легче предупредить, чем потом долгие месяцы, а то и годы лечить ее. В рейтинге самых нелюбимых врачей первые строчки занимают стоматологи и гинекологи.
 Практически каждая здоровая женщина имеет возможность и силы кормить своего ребёнка грудью. Но в силу различных обстоятельств зачастую женщины отказываются от грудного вскармливания ребёнка и переходят на кормление при помощи молочных смесей. Одними из самых распространённых проблем, по которой грудное вскармливание ребёнка становится трудным или даже невозможным, являются трещины сосков у кормящих матерей.
Практически каждая здоровая женщина имеет возможность и силы кормить своего ребёнка грудью. Но в силу различных обстоятельств зачастую женщины отказываются от грудного вскармливания ребёнка и переходят на кормление при помощи молочных смесей. Одними из самых распространённых проблем, по которой грудное вскармливание ребёнка становится трудным или даже невозможным, являются трещины сосков у кормящих матерей.
 Вы, конечно, знаете, что гинеколога и стоматолога надо посещать раз в пол года, но почему-то вот уже 5 лет не были в своей поликлинике?! Роль плановой диспансеризация в здоровье женщины, нельзя преуменьшать – ведь прописную истину «Лучший способ вылечить заболевание – это не допустить его возникновения» - сложно оспаривать. Для того, чтобы вы не запустили свое здоровье и не тратили свое время и деньги зря, надо не забывать о плановом посещении врачей.
Вы, конечно, знаете, что гинеколога и стоматолога надо посещать раз в пол года, но почему-то вот уже 5 лет не были в своей поликлинике?! Роль плановой диспансеризация в здоровье женщины, нельзя преуменьшать – ведь прописную истину «Лучший способ вылечить заболевание – это не допустить его возникновения» - сложно оспаривать. Для того, чтобы вы не запустили свое здоровье и не тратили свое время и деньги зря, надо не забывать о плановом посещении врачей.
Поэтому для всех женщин у которых нет хронических заболеваний и прочих серьезных проблем со здоровьем рекомендуется следующий план диспансеризации:
 Кандидоз или как называют в народе - молочница, вызывается грибком - Кандида. Размножаясь образует мицелий молочно белого цвета, расположенный на слизистых, отсюда и название. Данный грибок является условно - патогенным, т.е. в норме присутствует на слизистой и коже у человека. При благоприятной обстановке он начинает активно размножаться. Это возникает при снижении местного или общего иммунитета. Также проявляется как следствие аллергии на представителей грибов этого рода - протекает с яркой клиникой и частыми рецидивами.
Кандидоз или как называют в народе - молочница, вызывается грибком - Кандида. Размножаясь образует мицелий молочно белого цвета, расположенный на слизистых, отсюда и название. Данный грибок является условно - патогенным, т.е. в норме присутствует на слизистой и коже у человека. При благоприятной обстановке он начинает активно размножаться. Это возникает при снижении местного или общего иммунитета. Также проявляется как следствие аллергии на представителей грибов этого рода - протекает с яркой клиникой и частыми рецидивами.

Роды дома. Роды в воде. Естественно ли это? Давайте попробуем разобраться. Все девять месяцев будущие мамочки озабочены разного рода вопросами. На кого будет похож малыш, какого цвета будут глазки, кучерявые волосы или прямые и еще куча всего. Но конечно же на первом месте желание обеспечить нормальные роды результатом которых будет здоровый малыш. Некоторые пары представить себе не могут роды вне медицинских учреждений, другие же наоборот слышать ничего не хотят о роддомах предпочитая им родоразрешение в домашней обстановке.
Не так давно люди, которые болели лейкозом, были обречены, так как те методы, которые обычно применяли для лечения злокачественных опухолей, совершенно не подходили для оказания помощи больным лейкозом. Но благодаря достижениям ученых еще в конце двадцатого века была разработана методика лечения лейкоза, да притом ни одна. Новые методики гарантируют не только поддержание здоровья, но и полнейшее выздоровление. Современные методы лечения лейкоза подходят и для детей, которые страдают острой формой заболевания.
Не так давно люди, которые болели лейкозом, были обречены, так как те методы, которые обычно применяли для лечения злокачественных опухолей, совершенно не подходили для оказания помощи больным лейкозом. Но благодаря достижениям ученых еще в конце двадцатого века была разработана методика лечения лейкоза, да притом ни одна. Новые методики гарантируют не только поддержание здоровья, но и полнейшее выздоровление. Современные методы лечения лейкоза подходят и для детей, которые страдают острой формой заболевания.

Кликаем по кнопке "Добавить на Яндекс" и виджет установится у Вас на странице и Вы будете видеть свежие статьи с сайта

